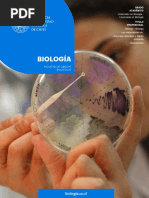

0% encontró este documento útil (0 votos)
520 vistas1 páginaFormación en Ciencias Naturales y Matemáticas
El documento presenta la malla curricular del College de Ciencias Naturales y Matemáticas de una universidad. La malla describe los cursos que los estudiantes deben tomar semestre a semestre a lo largo de hasta 12 semestres. Incluye cursos de matemáticas, ciencias básicas y cursos de especialización (majors). Al finalizar, los estudiantes obtienen una Licenciatura en Ciencias Naturales y Matemáticas y pueden elegir una de las diversas majors listadas, como Agronomía, Biología, Física, Estadí
Cargado por
Lorenza Juliette Cortés GonzálezDerechos de autor
© © All Rights Reserved
Nos tomamos en serio los derechos de los contenidos. Si sospechas que se trata de tu contenido, reclámalo aquí.
Formatos disponibles
Descarga como PDF, TXT o lee en línea desde Scribd
0% encontró este documento útil (0 votos)
520 vistas1 páginaFormación en Ciencias Naturales y Matemáticas
El documento presenta la malla curricular del College de Ciencias Naturales y Matemáticas de una universidad. La malla describe los cursos que los estudiantes deben tomar semestre a semestre a lo largo de hasta 12 semestres. Incluye cursos de matemáticas, ciencias básicas y cursos de especialización (majors). Al finalizar, los estudiantes obtienen una Licenciatura en Ciencias Naturales y Matemáticas y pueden elegir una de las diversas majors listadas, como Agronomía, Biología, Física, Estadí
Cargado por
Lorenza Juliette Cortés GonzálezDerechos de autor
© © All Rights Reserved
Nos tomamos en serio los derechos de los contenidos. Si sospechas que se trata de tu contenido, reclámalo aquí.
Formatos disponibles
Descarga como PDF, TXT o lee en línea desde Scribd